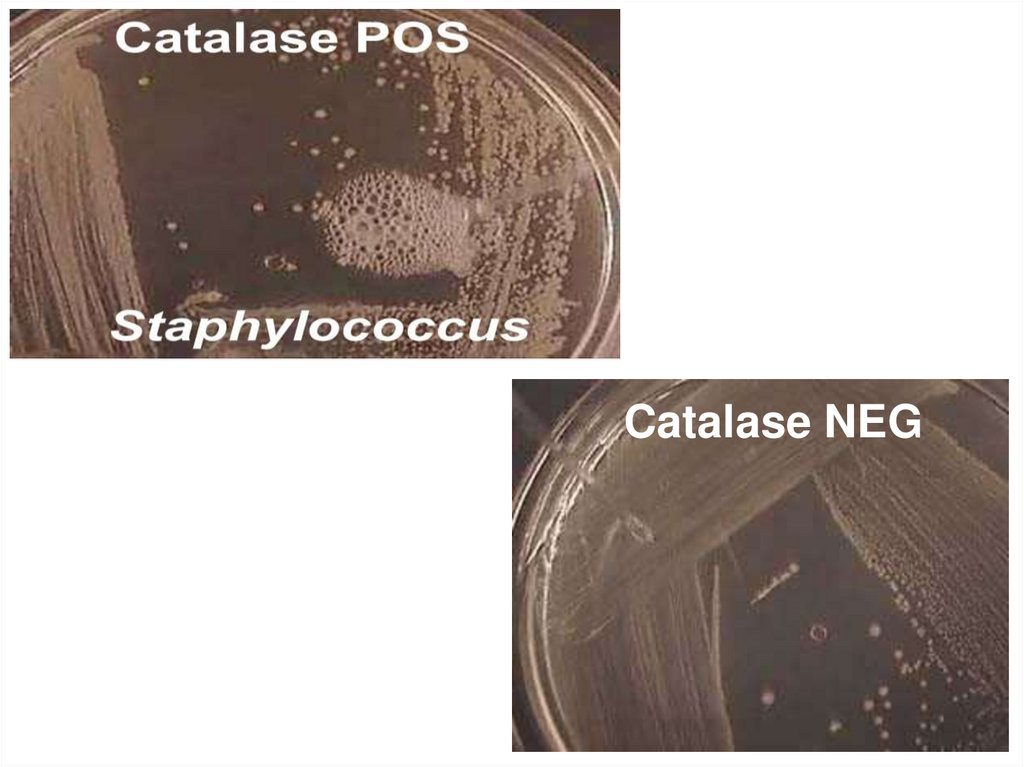
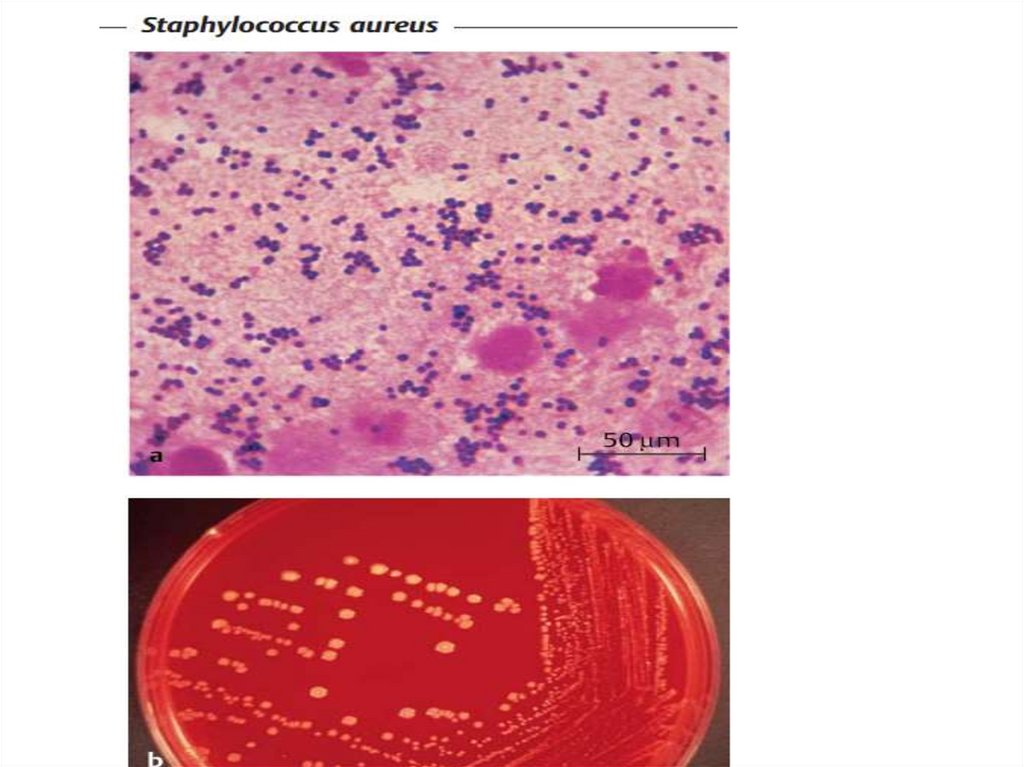
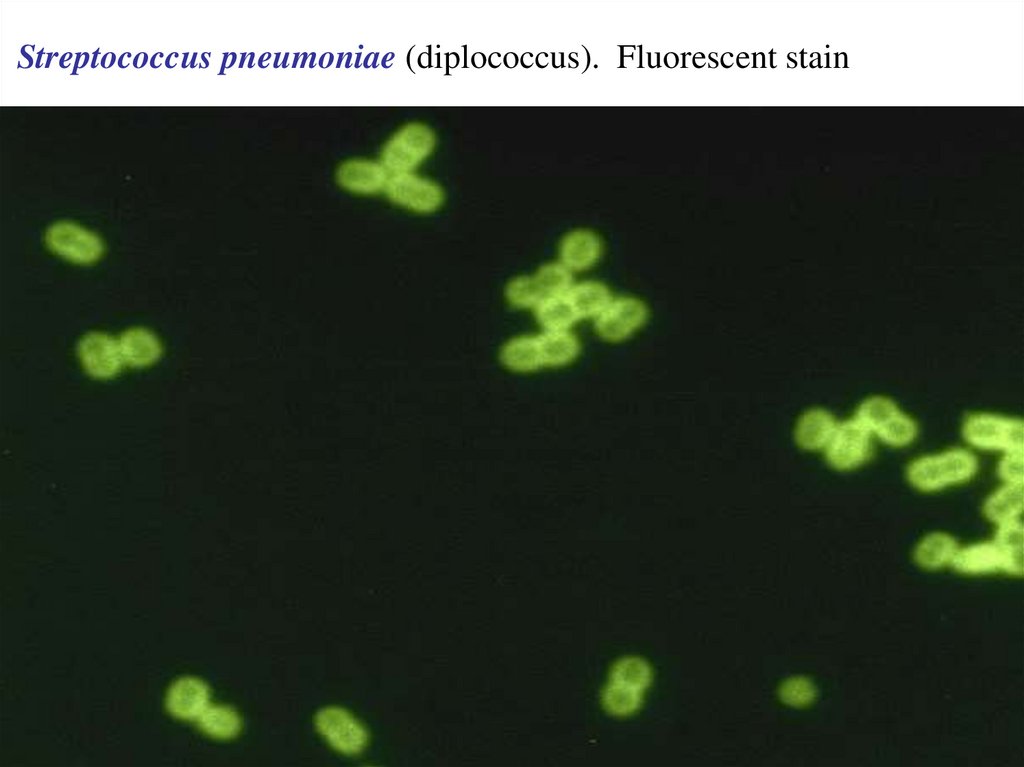

Similar presentations:
Инфекцияның көзі бойынша жіктелуі
1.
Биомедицина кафедрасыШартты патогенді микроорганизмдер.
Ауруханаішілік инфекциялардың пайда болуындағы ЖПМ
рөлі. Ауруханаішілік инфекциясының қоздырғыштарының
патогенділік факторлары, микробиологиялық
диагностикасы.
Abdulina G.A
2. Инфекция
• Инфекция• Инфекциялық процесс
• Инфекциялық ауру
3. Инфекцияның көзі бойынша жіктелуі:
• зоонозды• антропонозды
• , сапронозды
Көздыргыш бойынша жіктелуі:
бактериальды, вырусты т.б.
4. Берілу жолдары
1. Тікелей және тікелей емес контакт2. Жыныстық жол
3. Ауа-тамшылы
4. Трансмиссивті (Arthropod vectors)
5. Парентеральді
6. Фекальді-оральді
7. Вертикальді: пренатальді,
перинатальді және постнатальді.
5.
Эпидемиялык процессИнфекцияның
көзі
қоздырғыш
Берілу
жолдары
Кіру қақпасы
арқылы
сезімтал ағза
6.
Pathogenicity – патогеннің ауру тудыруғапотенциалды қабілеті.
Virulence – патогенділіктің өлшемі, дәрежесі:
LD50, LD min, LD abc, ID50, ID min, ID abc.
LD50 г/кг ботулотоксин 0,000000001
LD50г/кг полоний0,00000001
Инфективтілік
Инвазивтілік
7.
Вирулентті факторлар:1. Адгезия және колонизация факторлары
2. Сыртқы мембрана протеиндері (Outer membrane
proteins (OMP)) грам теріс бактерия OMP бөледі,
негізінде олар комплементті белсендіріп лизисқа
ұшыратады.
3.Инвазия факторлары: бактерияны жасуша ішіне
енуге жауапты.Агрессия ферменттер
8.
4.Капсулар: фагоцитоздан қорғайды.5.Сидифорлар:
темірді
байланыстырушы
факторлар.
Темір
ағзаның
ақуыздары
(лактоферин,
трансферин,
геммоглабин
)
құрамына кіреді.
6.Биоүлбір (Biofilms) бактерияның
коллонизациясына жауапты және көптеген АБ
резистенттілік береді.
7.Эндотоксин: ЛПС грам теріс бактериялардың
эндотоксикалық әсері бар: температураны
көтереді, эндотоксикалық шокты тудырады, қан
қысымын өзгертеді.
9.
Basic structure of endotoxin (lipopolysaccharide)from Gram-negative bacteria.
polysaccharide; hence, the alternate name
lipopolysaccharide
10.
Endotoxins пирогнедік әсері1. A macrophage ingests a gram-negative bacteria
2. The bacterium is degraded in a vacuole, releasing
endotoxins that induce the macrophage to produce
cytokines IL1 and TNF-a
3. The cytokines are released into the blood· and travel
to the hypothalamus of the brain.
4. The cytokines induce the hypothalamus to produce
prostaglandins, which reset the body's '"thermostat to
a higher temperature, producing fever.
11.
12.
The part of the Gram negative cell wall that is endotoxin is thelipopolysaccharide (LPS). LPS consists of three components:
13.
Нозокомиальді немесе ауруханаішілікинфекциялар
1. Негізінде ауруханада емдеу нәтижесінде
пайда болатын инфекциялар.
2. 5-15% ауруханаға жатқызылған
пациенттер нозокомиальді инфекцияға ие
болады.
3. Оппортунистік полирезистентті грам теріс
бактериялар мен грам оң кокктар
ауруханаішілік инфекяиларға жауапты
болады.
14. Classification.
• Family Micrococcaceae• Genus Staphylococcus
• Species more than 30 (S. aureus,
S.heamolyticus S. epidermidis, and S.
saprophyticus)
15. Coagulase белсенділігі
StaphylococcI екі топқа бөлінеді:1. Coagulase-positive S aureus негізгі адам
патогені.
2. Coagulase-negative staphylococci (CoNS) 30
артық түрі бар. Поталогиялық маңызы бар:
S.epidermitis және S. saprophyticus
16. Tube Coagulase Test
Staphylococcusaureus
Coagulase NEG
Coagulase POS
17. Physiology/Structure
• Gram (+) cocci жүзім тәріздес• Facultative anaerobes
• Catalase (+)
• Қозғалмайды
• Спора түзбейді
• Coagulase (+) S. aureus
• Β‐hemolytic
18. Staphylococci microscopy
19. S aureus вирулентті факторлары
(1) Беткейлік ақуыздар (FnBP) . Кілегейліқабықшаға жабысуына жауапты.
(2) Капсулар, protein A фагоцитоздан қорғайды.
(3) Инвазия факторлары оғын агрессиялық
ферменттер жатады Staphylokinase, proteases,
lipase, Hyaluronidase, (Deoxyribonuclease (DNase)
and a fatty acid modifying enzyme (FAME). The
FAME enzyme may be important in abscesses және
т.б.).
( 4)Токсиндер тіндеді зақымдайды және
токсикалық әсерін көрсетеді.
20. S aureus toxins
Мембрананы бұзатын токсиндер• hemolytic and leukotoxic (PVl)
leukocidin
• Toxic Shock Syndrome Toxin
( superantigen TSST‐1)
• SSSST Exfoliatin
• Enterotoxin A, B, C, D, E and G
21. SSSS in neonates
22.
23.
S aureus тудырады:Фурункул, абцесс, флигмона,
тонзилит.
Остеомиелит, эндокардит
Пневмония
Сепсис
Хирургиялық госпитальді жарақат
инфекциялары
Токсикалық шоктың синдромы
Тағамдық улану
Scalded Skin Syndrome және т.б.
24.
S. Epidermidis, S.haemolyticusмедициналық манипуляциядан
инструменттерден жұқтыратын
патоген (катетер, стендтер және
т.б.).
S. saprophiticus қыз балаларда
цистит тудырады.
25.
SKIN LESIONSimpetigo (bullous & pustular
26.
27.
ДиагностикасыA Gram әдісі
B) Бактериологиялық (маннитол
тұзды агарға егу және
идентификация өткізу)
Differentiation
catalase
coagulase
phage typing
Rapid diagnosis and typing Real-time
PCR Maldi
28. Staphylococcal Lab ID Diagnostic Tests
Microscopic Gram stain29. MANNITOL SALTS AGAR (MSA)
30.
Catalase NEG31.
StaphylococcusStaphylococcus
aureus
aureus
Coagulase
CoagulasePOS
POS
Coagulase NEG
32.
33.
Isolation and IdentificationCulture media
1. Blood agar hemolysis of blood
cells can be very useful as an
identification test
2. Chistovich agar containing 7.5%
sodium chloride –selective
medium
3. MPA – pigment production
34.
Antibiotic ResistanceMultiple antibiotic resistance is increasingly
common in S aureus and S epidermidis.
Methicillin resistance is indicative of multiple
resistance. Methicillin-resistant S aureus (MRSA)
causes outbreaks in hospitals and can be
epidemic.
35.
VaccinesNo vaccine is currently available to combat
staphylococcal infections.
Hyperimmune serum from human volunteer
donors. which could be given to patients in
hospital before surgery
A vaccine based on fibronectin binding
protein induces protective immunity against
mastitis in cattle and might also be used as a
vaccine in humans.
36.
37.
38.
StreptococcusStreptococcus pyogenes infections :pharyngitis, scarlet fever
(rash), impetigo, cellulitis, or erysipelas., necrotizing fasciitis,
myositis and streptococcal toxic shock syndrome. acute
rheumatic fever and acute glomerulonephritis.
S agalactiae may cause meningitis, neonatal sepsis, and
pneumonia in neonates; adults may experience vaginitis,
urinary tract infection, skin infection, and endocarditis.
Viridans streptococci can cause endocarditis
Enterococcus is associated with urinary tract and biliary tract
infections.
Anaerobic streptococci participate in mixed infections of the
abdomen, pelvis, brain, and lungs.
39.
Streptococcus in chains40.
Streptococcus pneumoniae (diplococcus). Fluorescent stain41.
StructureStreptococci are Gram-positive,
nonmotile, nonsporeforming, catalasenegative cocci that occur in pairs or
chains. Most streptococci are facultative
anaerobes, and some are obligate (strict)
anaerobes. Most require enriched media
(blood agar). Group A streptococci have a
hyaluronic acid capsule
42.
Classification and Antigenic TypesStreptococci are classified on the basis of
colony morphology, hemolysis, biochemical
reactions, and (most definitively) serologic
specificity. They are divided into three groups
by the type of hemolysis on blood agar:
• b-hemolytic (clear, complete lysis of red
cells)
• a- hemolytic (incomplete, green hemolysis)
• g -hemolytic (no hemolysis)..
43.
Serologic grouping (Lancfield) is based on antigenicdifferences in cell wall carbohydrates (groups A to V)
Groupable streptococci
A -Streptococcus pyogenes
B -S agalactiae
D - Enterococcus fecalis most important
C, G, F -rare
Non-groupable
S. pneumoniae and Viridans streptococci e.g. S. mutans
dental caries
44.
Antigenic structures on S. pyogenes• Capsule
• Group specific cell wall antigen
• Type specific cell wall antigens
• M protein
• T protein
• R protein
• Nucleoprotein
• Lipoteichoic acid
45. Antigenic structure of S. pyogenes
46.
Type Specific Cell Wall AntigensM protein is the chief virulence factor of group A
streptococci. M protein resist phagocytosis by PMN
leukocytes and multiply rapidly in fresh human blood.
GAS may be divided into serotypes based onthe M protein
molecule. More than 80 such serotypes are currently
recognised.
T Proteins are resistant to trypsin and pepsin but are acid
and heat labile. This antigen has no relationship with
virulence of group A streptococci.
R Proteins are nonprotective. R antigens may be
biologically defective or inactive forms of M proteins
Lipoteichoic Acid is expressed on the surface of group A
streptococci and plays a critical role in the adhesion
colonization of infection
47.
Cultural CharactersS.pyogenes is facultative anaerobe and best growth
is achieved at pH 7.4-7.6 and at temperature of 37°C.
S.pyogenes is invariably beta haemolytic and the
zone of haemolysis is far greater than the size of colony.
The colonies are around 1 mm in diameter, surrounded
by a zone of clear haemolysis, semi-transparent, low
convex, discrete and vary in appearance.Three types of
colonies are encountered:
Mucoid colonies are produced by strains forming
large amounts of hyaluronic acid. Strains with M protein
give rise to matt colonies whereas those without it
produce glossy colonies.
48.
49.
PathogenesisStreptococci are members of the normal flora.
Virulence factors of group A streptococci include
(1)M protein and lipoteichoic acid for attachment;
(2) a hyaluronic acid capsule that inhibits phagocytosis;
(3) other extracellular products, such as pyrogenic
(erythrogenic) toxin. Three pyrogenic exotoxins of S
pyogenes (SPEs) are recognized: types A, B, C
which causes the rash of scarlet fever;
(4) streptokinase, streptodornase (DNase B), and
streptolysins.
Some strains are nephritoxigenic.
Nongroup A strains have no defined virulence factors
50.
Toxins and enzymes liberated bygroup A streptococci
• Haemolysins (Streptolysin): Streptolysin
O, Streptolysin S
• Erythrogenic toxin (Pyrogenic exotoxin)
• Streptokinase (Fibrinolysin)
• Deoxyribonuclease (Streptodornase)
• Hyaluronidase
• Proteinase
• Serum opacity factor
• Neuraminidase
• Nicotinamide adenine dinucleoitidase
51.
Streptococcal pyrogenic exotoxins effect onimmune system: enhancement of susceptibility to
endotoxic shock, blockade of reticulo-endothelial
system and alterations in the T cell function.
These toxins are produced by strains of group A
streptococci which are carrying temperate phage
in their genome.
Toxin caused red reaction in the skin of
nonimmune individual (positive Dick test) and
no reaction in individuals with immunity
(negative Dick test).

medicine
medicine








